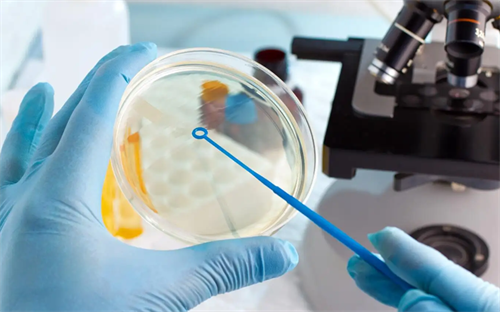

然而,鲜胚移植后的一周内同房,可能会影响胚胎着床成功率,甚至增加流产风险。鲜胚移植后一周内同房可能会影响胚胎着床成功率,增加流产风险。。


然而,鲜胚移植后的一周内同房,可能会影响胚胎着床成功率,甚至增加流产风险。鲜胚移植后一周内同房可能会影响胚胎着床成功率,增加流产风险。。

子宫腺肌症不做手术直接试管助孕,成功率到底有多少?

多囊卵巢综合征做试管容易腹水?教你如何科学促排避坑

老公无精症只能做供精试管吗?二代试管穿刺取精成功率大揭秘

移植后第5天肚子刺痛是着床了吗?出现这3种信号要恭喜你

腺肌症痛经严重:打达菲林缩小子宫后移植,成功率能翻倍吗?

卵巢早衰借卵生子:孩子会遗传供卵者的长相吗?

2026成都供卵市场调查:那些承诺“不用排队”的机构可信吗?

老公弱精+精子碎片率高,二代试管能筛选出好精子吗?

移植后小腹坠胀像来姨妈,这次是不是又失败了?

上海供卵试管中介的千层套路!如何一眼识别“挂羊头卖狗肉”
添加微信好友,商谈详细合作细则
